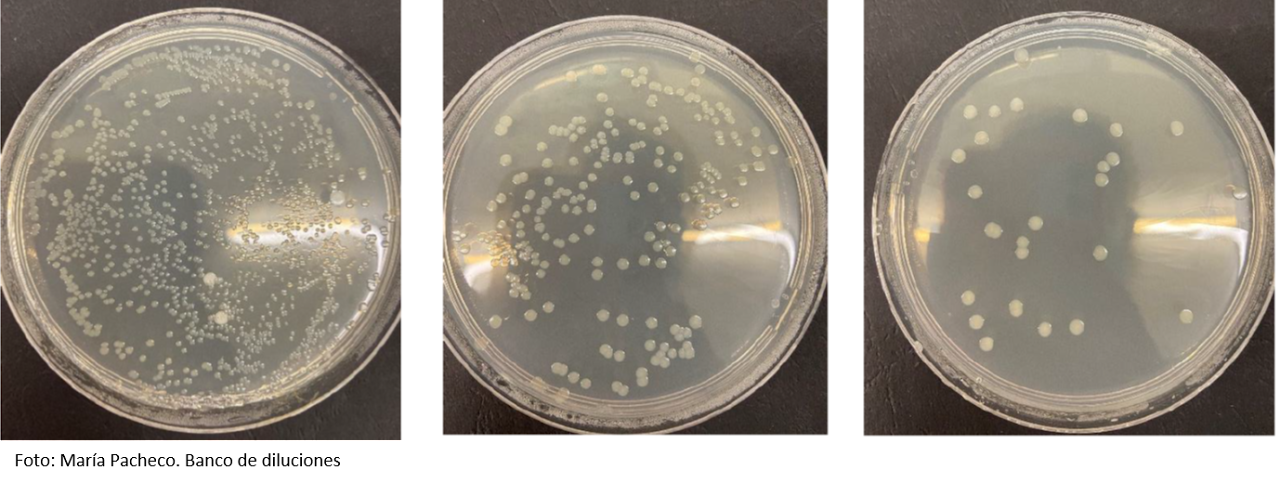

Práctica 8: Aislamiento bacteriano por dilución
13/11/24
INTRODUCIÓN:
La siembra por inundación se realiza sobre medios sólidos en placa. Consiste en verter una suspensión bacteriana sobre el medio hasta que lo cubra totalmente. Es una técnica especialmente útil en los antibiogramas.

OBJETIVOS:
- Aprender a diluir un cultivo de bacterias para su aislamiento y cuantificación.
- Aprender a hacer un recuento de las unidades formadoras de colonias (UFC).
MATERIALES:
- Medio de cultivo líquido.
- 7 tubos rotulados con números del 1 al 7.
- 3 placas de Petri con agar nutritivo como medio.
- Gradilla.
- Estufa.
- Micropipeta (100-1000μl).
- Puntas azules.
- Vaso de precipitados con agua destilada.
- Pipeta de vidrio de 5 ml.
- Campana extractora.
- P. fluorescens.
- Vortex (en este caso se procedió de manera manual, aunque hay más riesgo de derrame).
PROCEDIMIENTO:
1. En una gradilla se tienen siete tubos de base cónica numerados del 1 al 7, en los cuales se van a hacer una serie de diluciones.
2. En cada uno de los siete tubos se depositan 4,5 ml de agua destilada (con una pipeta de vidrio de 5 ml) y se lleva la gradilla a la campana.
3. Se coge una micropipeta de 100-1000 μl para coger 500 μl del medio líquido de la bacteria (Pseudomonas fluorescens).
4. Después de coger los 500 μl del medio líquido, se echan en el tubo 1, se homogeniza y se desecha la punta azul en el contenedor amarillo (para homogeneizar se pone el dedo encima y se agita).
5. Se coge otra punta azul, y se traspasan 500 μl del tubo 1 al tubo 2, y se repite el procedimiento.
6. Se hace lo mismo con el resto de tubos.
7. Se cogen tres placas de agar nutritivo, cada una marcada con el nombre de cada grupo, la fecha y, además, en la primera placa debe poner "tubo 5", en la segunda "tubo 6", y en la última "tubo 7".
8. El tubo 5 se vierte entero en la placa correspondiente y se gira la placa unas 5-6 veces en sentido horario, y 5-6 veces en sentido contrario.
9. Se repite con los tubos 6 y 7 en sus respectivas placas.
10. Cuando están las tres placas listas, se llevan a la estufa durante 24 horas a 37ºC.

Ahora se puede visualizar un vídeo de la práctica. El vídeo está realizado junto al grupo de Laboratorios Flash.
RESULTADOS:
INTERPRETACIÓN DE RESULTADOS:
En ninguna placa se observan colonias. Si hubiera salido bien, debería haber entre 30 y 300 colonias en cada una. Si en una el número fuese superior a 300, se reportaría como incontable. La siguiente foto es un ejemplo de lo que debería haber salido.